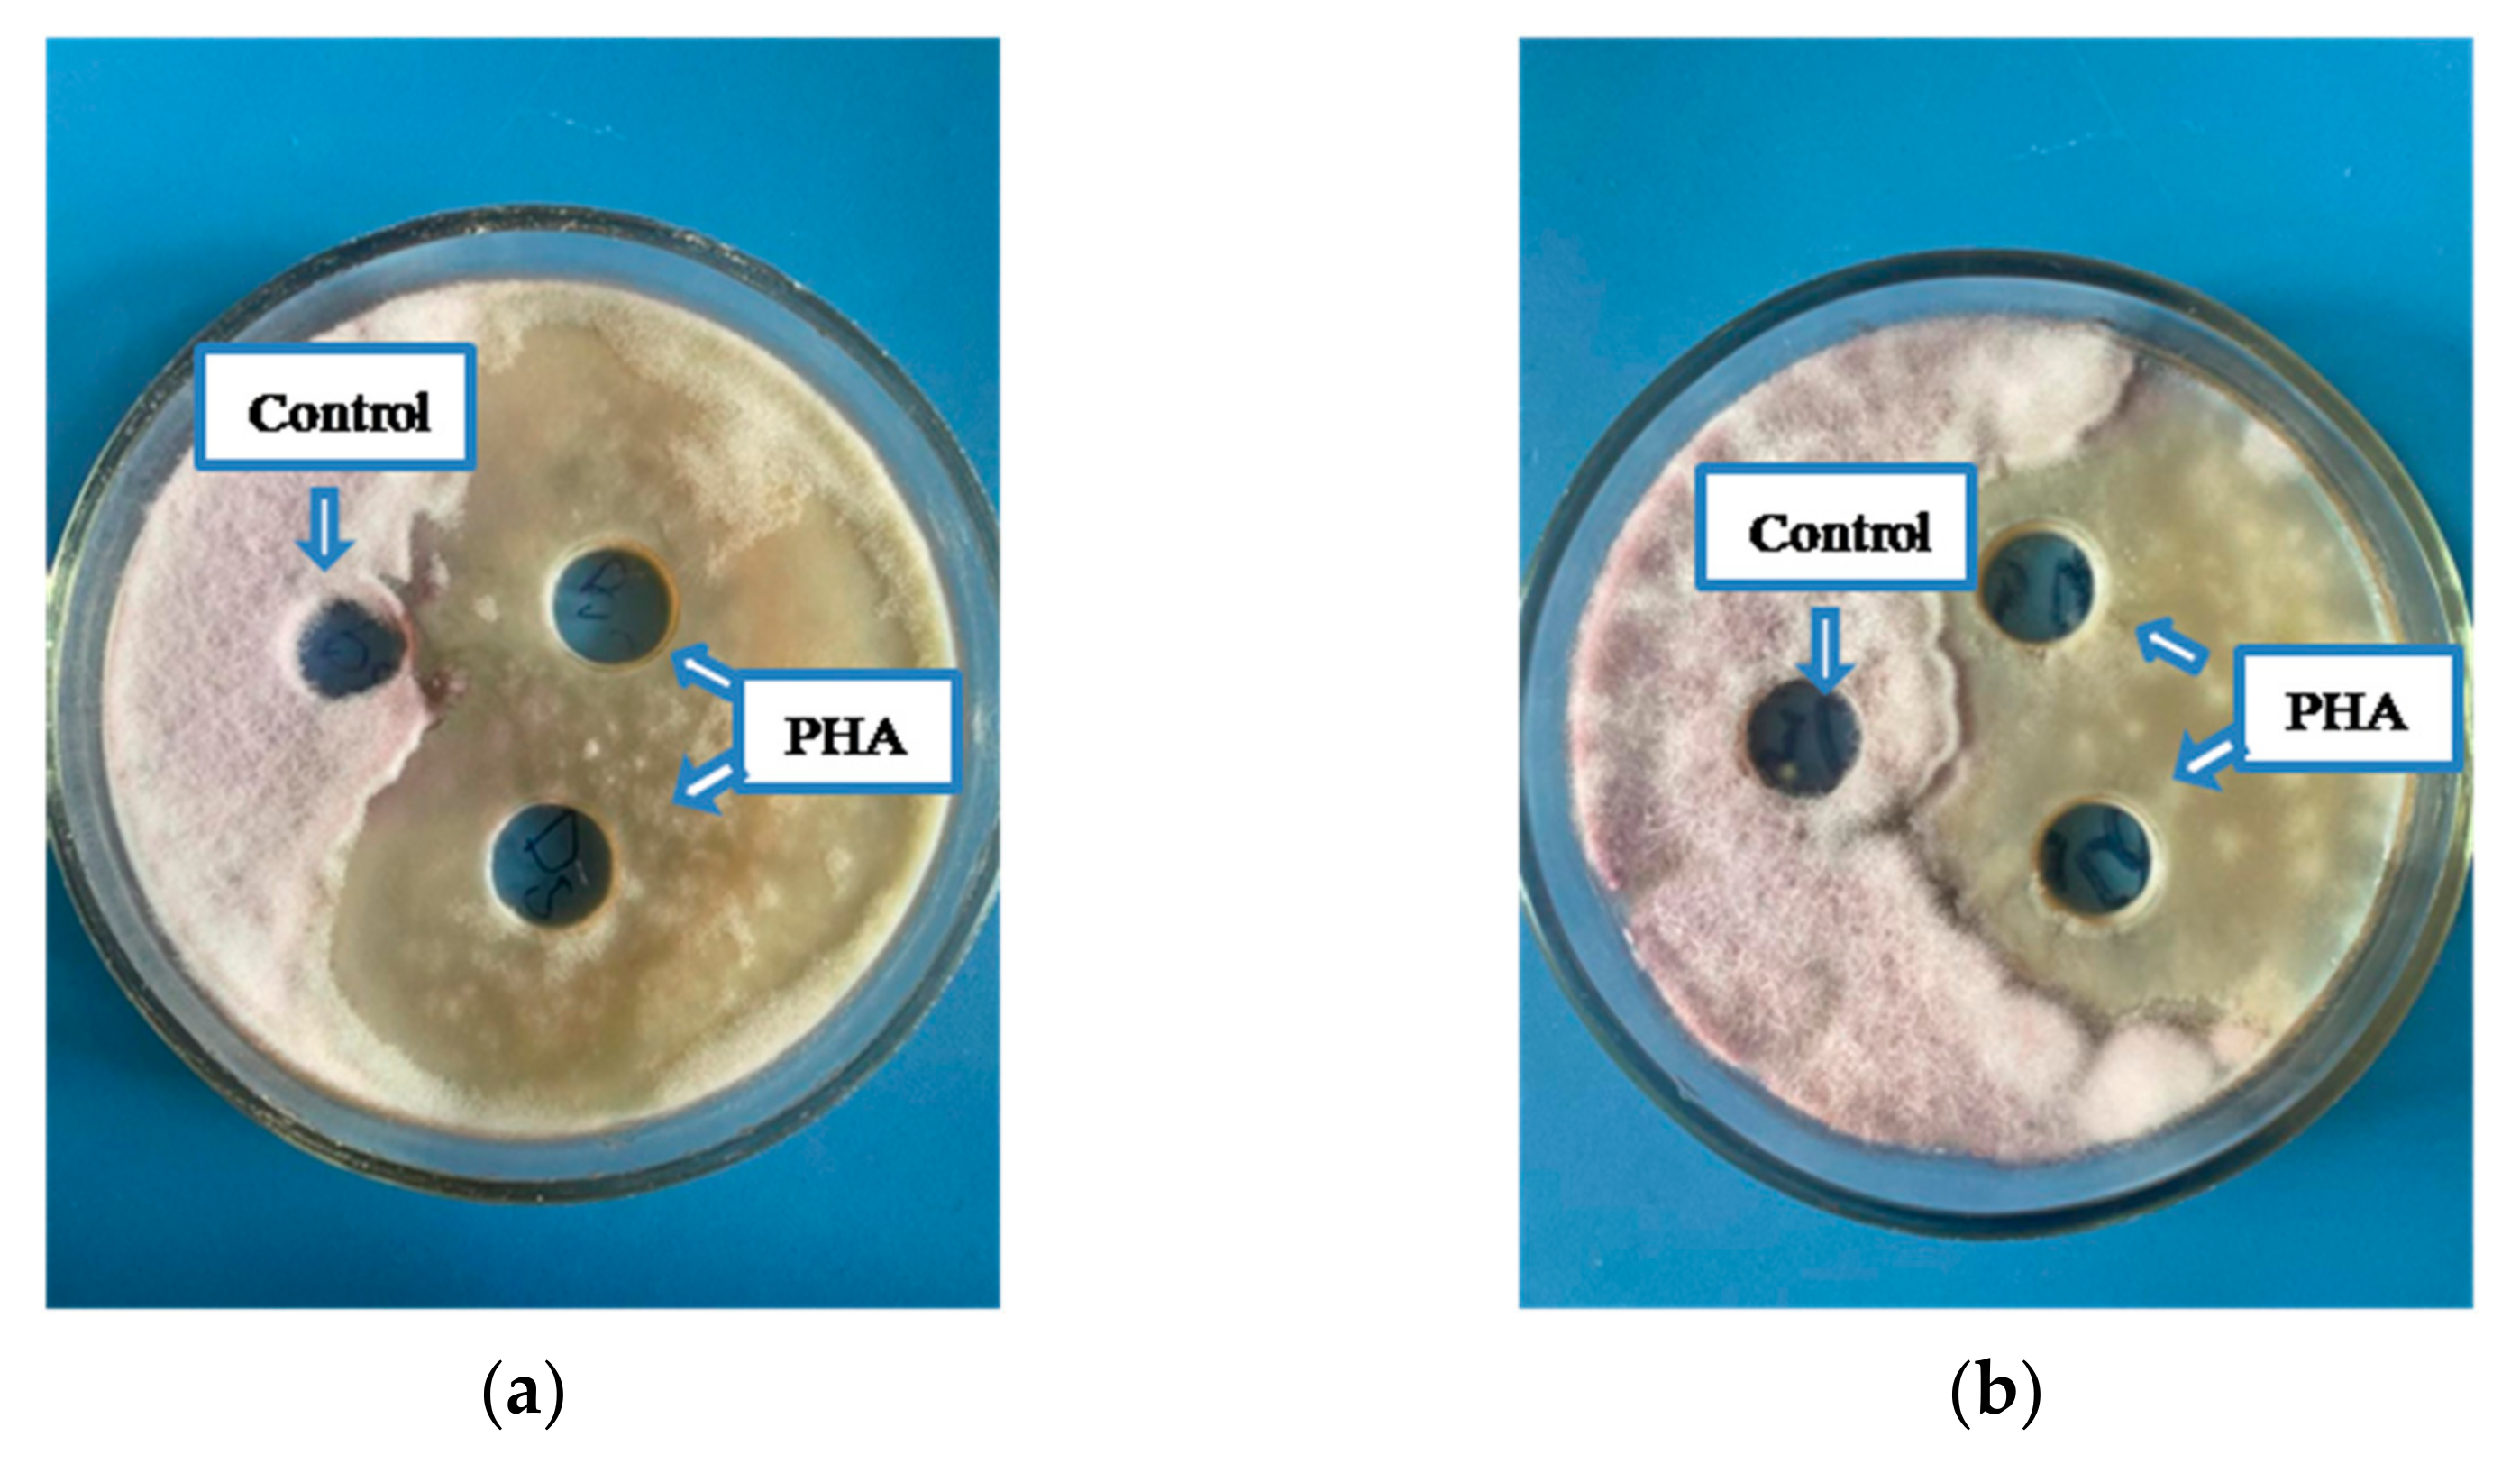

Plant Probiotic Endophytic Pseudomonas flavescens D5 Strain for Protection of Barley Plants from Salt Stress
Abstract
1. Introduction
2. Materials and Methods
2.1. Endophyte Isolation
2.2. Determination of Halotolerance of Microorganisms
2.3. 16S rRNA Gene Sequencing and Phylogenetic Analysis
2.4. IAA Production Assay
2.5. Detection of Amylolytic Ability
2.6. Detection of Cellulolytic Ability
2.7. Detection of Proteolytic Enzymes in Microorganisms
2.8. Determination of the Ability of Microorganisms to Perform Phosphate Mobilization
2.9. PHA Production Assay
2.10. Antifungal Activity of Bacterial PHA
2.11. Pot Experiment
2.12. Determination of Chlorophyll Concentration
2.13. Determination of Free Proline Concentration
2.14. Preparation of the Extract for The determination of Antioxidant Enzymes
2.15. Investigation of Catalase Activity
2.16. Investigation of Ascorbate Peroxidase Activity
2.17. Investigation of Guaiacol Peroxidase Activity
2.18. Determination of the Protein Amount
2.19. Element Content Assay
Statistical Analysis
3. Results and Discussion
3.1. Isolation and Plant Probiotic Properties of Halotolerant Bacteria
3.2. Antifungal Activity of PHA
3.3. Plant Response to Bacterial Application
4. Conclusions
Author Contributions
Funding
Data Availability Statement
Conflicts of Interest
References
- Food and Agriculture Organization SOILS PORTAL. Available online: https://www.fao.org/soils-portal/data-hub/soil-maps-and-databases/global-map-of-salt-affected-soils/en/ (accessed on 24 October 2022).
- Behera, T.K.; Krishna, R.; Ansari, W.A.; Aamir, M.; Kumar, P.; Kashyap, S.P.; Pandey, S.; Kole, C. Approaches Involved in the Vegetable Crops Salt Stress Tolerance Improvement: Present Status and Way Ahead. Front. Plant Sci. 2022, 12, 787292. [Google Scholar] [CrossRef]
- Kumar, A.; Singh, S.; Gaurav, A.K.; Srivastava, S.; Verma, J.P. Plant Growth-Promoting Bacteria: Biological Tools for the Mitigation of Salinity Stress in Plants. Front. Microbiol. 2020, 11, 1216. [Google Scholar] [CrossRef]
- Singh, S.; Jaiswal, D.K.; Krishna, R.; Mukherjee, A.; Verma, J.P. Restoration of Degraded Lands through Bioenergy Plantations. Restor. Ecol. 2020, 28, 263–266. [Google Scholar] [CrossRef]
- Brazhnikova, Y.V.; Shaposhnikov, A.I.; Sazanova, A.L.; Belimov, A.A.; Mukasheva, T.D.; Ignatova, L.V. Phosphate Mobilization by Culturable Fungi and Their Capacity to Increase Soil P Availability and Promote Barley Growth. Curr. Microbiol. 2022, 79, 240. [Google Scholar] [CrossRef]
- Ignatova, L.; Brazhnikova, Y.; Berzhanova, R.; Mukasheva, T. The Effect of Application of Micromycetes on Plant Growth, as Well as Soybean and Barley Yields. Acta Biochim. Pol. 2015, 62, 669–675. [Google Scholar] [CrossRef] [PubMed]
- Belimov, A.A.; Dodd, I.C.; Hontzeas, N.; Theobald, J.C.; Safronova, V.I.; Davies, W.J. Rhizosphere Bacteria Containing 1-Aminocyclopropane-1-carboxylate Deaminase Increase Yield of Plants Grown in Drying Soil via Both Local and Systemic Hormone Signalling. New Phytol. 2009, 181, 413–423. [Google Scholar] [CrossRef] [PubMed]
- Verma, H.; Kumar, D.; Kumar, V.; Kumari, M.; Singh, S.K.; Sharma, V.K.; Droby, S.; Santoyo, G.; White, J.F.; Kumar, A. The Potential Application of Endophytes in Management of Stress from Drought and Salinity in Crop Plants. Microorganisms 2021, 9, 1729. [Google Scholar] [CrossRef]
- Tufail, M.A.; Bejarano, A.; Shakoor, A.; Naeem, A.; Arif, M.S.; Dar, A.A.; Farooq, T.H.; Pertot, I.; Puopolo, G. Can Bacterial Endophytes Be Used as a Promising Bio-Inoculant for the Mitigation of Salinity Stress in Crop Plants-A Global Meta-Analysis of the Last Decade (2011–2020). Microorganisms 2021, 9, 1861. [Google Scholar] [CrossRef]
- Lata, R.; Chowdhury, S.; Gond, S.K.; White, J.F. Induction of Abiotic Stress Tolerance in Plants by Endophytic Microbes. Lett. Appl. Microbiol. 2018, 6, 268–276. [Google Scholar] [CrossRef] [PubMed]
- Eid, A.M.; Salim, S.S.; Hassan, S.E.; Ismail, M.A.; Fouda, A. Role of Endophytes in Plant Health and Abiotic Stress Management. In Microbiome in Plant Health and Disease; Kumar, D., Prasad, R., Kumar, M., Choudhary, D., Eds.; Springer: Singapore, 2019; pp. 119–144. [Google Scholar]
- Rahman, M.; Sabir, A.; Mukta, J.A. Plant Probiotic Bacteria Bacillus and Paraburkholderia Improve Growth, Yield and Content of Antioxidants in Strawberry Fruit. Sci. Rep. 2018, 8, 2504. [Google Scholar] [CrossRef] [PubMed]
- de Souza Vandenberghe, L.P.; Garcia, L.M.B.; Rodrigues, C.; Camara, M.C.; de Melo Pereira, G.V.; de Oliveira, J.; Soccol, C.R. Potential Applications of Plant Probiotic Microorganisms in Agriculture and Forestry. AIMS Microbiol. 2017, 3, 629–648. [Google Scholar] [CrossRef]
- Jha, Y.; Subramanian, R.B. PGPR Regulate Caspase-Like Activity, Programmed Cell Death, and Antioxidant Enzyme Activity in Paddy under Salinity. Physiol. Mol. Biol. Plants 2014, 20, 201–207. [Google Scholar] [CrossRef] [PubMed]
- Kang, S.M.; Radhakrishnan, R.; Khan, A.L.; Kim, M.J.; Park, J.M.; Kim, B.R. Gibberellin Secreting Rhizobacterium, Pseudomonas putida H2-3 Modulates the Hormonal and Stress Physiology of Soybean to Improve the Plant Growth under Saline and Drought Conditions. Plant Physiol. Biochem. 2014, 84, 115–124. [Google Scholar] [CrossRef] [PubMed]
- Yasmin, H.; Naeem, S.; Bakhtawar, M.; Jabeen, Z.; Nosheen, A.; Naz, R.; Hassan, M.N. Halotolerant Rhizobacteria Pseudomonas pseudoalcaligenes and Bacillus subtilis Mediate Systemic Tolerance in Hydroponically Grown Soybean (Glycine max L.) against Salinity Stress. PLoS ONE 2020, 15, e0231348. [Google Scholar] [CrossRef] [PubMed]
- Heydarian, Z.; Gruber, M.; Coutu, C.; Glick, B.R.; Hegedus, D.D. Gene Expression Patterns in Shoots of Camelina sativa with Enhanced Salinity Tolerance Provided by Plant Growth Promoting Bacteria Producing 1-Aminocyclopropane-1-carboxylate Deaminase or Expression of the Corresponding acdS Gene. Sci. Rep. 2021, 11, 4260. [Google Scholar] [CrossRef] [PubMed]
- Bano, A.; Fatima, M. Salt Tolerance in Zea mays (L). Following Inoculation with Rhizobium and Pseudomonas. Biol. Fertil. Soils 2009, 45, 405–413. [Google Scholar] [CrossRef]
- Rossi, M.; Borromeo, I.; Capo, C.; Glick, B.R.; Del Gallo, M.; Pietrini, F.; Forni, C. PGPB Improve Photosynthetic Activity and Tolerance to Oxidative Stress in Brassica napus Grown on Salinized Soils. Appl. Sci. 2021, 11, 11442. [Google Scholar] [CrossRef]
- Berni, R.; Hausman, J.-F.; Villas-Boas, S.; Guerriero, G. Impact of Pseudomonas sp. SVB-B33 on Stressand Cell Wall-Related Genes in Roots and Leaves of Hemp under Salinity. Horticulturae 2022, 8, 336. [Google Scholar] [CrossRef]
- Samaddar, S.; Chatterjee, P.; Choudhury, A.R.; Ahmed, S.; Sa, T. Interactions between Pseudomonas spp. and Their Role in Improving the Red Pepper Plant Growth under Salinity Stress. Microbiol. Res. 2019, 219, 66–73. [Google Scholar] [CrossRef]
- Alkowni, R.; Jodeh, S.; Hamed, R.; Samhan, S.; Daraghmeh, H. The Impact of Pseudomonas putida UW3 and UW4 Strains on Photosynthetic Activities of Selected Field Crops under Saline Conditions. Int. J. Phytoremediat 2019, 21, 944–952. [Google Scholar] [CrossRef]
- Roustakhiz, J.; Majnabadi, J.T. Cultivation of Chicory (Cichorium intybus L.), an Extremely Useful Herb. Int. J. Farm. Alli. Sci. 2017, 6, 14–23. [Google Scholar]
- Zhu, J.; Fan, Y.; Shabala, S.; Li, C.; Lv, C.; Guo, B.; Xu, R.; Zhou, M. Understanding Mechanisms of Salinity Tolerance in Barley by Proteomic and Biochemical Analysis of Near-Isogenic Lines. Int. J. Mol. Sci. 2020, 21, 1516. [Google Scholar] [CrossRef] [PubMed]
- Vaz, A.B.M.; da Costa, A.G.F.C.; Raad, L.V.V.; Góes-Neto, A. Fungal Endophytes Associated with Three South American Myrtae (Myrtaceae) Exhibit Preferences in the Colonization at Leaf Level. Fungal. Biol. 2014, 118, 277–286. [Google Scholar] [CrossRef] [PubMed]
- Wilson, K. Preparation of Genomic DNA from Bacteria. Curr. Protoc. Mol. Biol. 2001, 71, 27–31. [Google Scholar] [CrossRef] [PubMed]
- Tamura, K.; Stecher, G.; Peterson, D.; Filipski, A.; Kumar, S. MEGA6: Molecular Evolutionary Genetics Analysis Version 6.0. Mol. Biol. Evol. 2013, 30, 2725–2729. [Google Scholar] [CrossRef] [PubMed]
- Gordon, S.A.; Weber, R.P. Colorimetric Estimation of Indoleacetic Acid. Plant Physiol. 1951, 26, 192–195. [Google Scholar] [CrossRef] [PubMed]
- Ojovan, B.; Catana, R.; Neagu, S.; Cojoc, R.; Lucaci, A.I.; Marutescu, L.; Florescu, L.; Ruginescu, R.; Enache, M.; Moldoveanu, M. Metabolic Potential of Some Functional Groups of Bacteria in Aquatic Urban Systems. Fermentation 2021, 7, 242. [Google Scholar] [CrossRef]
- Morales, A.; Alvear, M.; Valenzuela, E.; Castillo, C.E.; Borie, F. Screening, Evaluation and Selection of Phosphate-Solubilising Fungi as Potential Biofertiliser. J. Soil Sci. Plant Nutr. 2011, 11, 89–103. [Google Scholar] [CrossRef]
- Sriyapai, T.; Chuarung, T.; Kimbara, K.; Samosorn, S.; Sriyapai, P. Production and Optimization of Polyhydroxyalkanoates (PHAs) from Paraburkholderia sp. PFN 29 under Submerged Fermentation. Electron. J. Biotechnol. 2022, 56, 1–11. [Google Scholar] [CrossRef]
- Balouiri, M.; Sadiki, M.; Ibnsouda, S.K. Methods for in Vitro Evaluating Antimicrobial Activity: A Review. J. Pharm. Anal. 2016, 6, 71–79. [Google Scholar] [CrossRef]
- Bradford, M.M. A Rapid and Sensitive Method for the Quantitation of Microgram Quantities of Protein Utilizing the Principle of Protein-Dye Binding. Anal. Biochem. 1976, 72, 248–254. [Google Scholar] [CrossRef] [PubMed]
- Dimkpa, C.; Weinand, T.; Asch, F. Plant-Rhizobacteria Interactions Alleviate Abiotic Stress Conditions. Plant Cell Env. 2009, 32, 1682–1694. [Google Scholar] [CrossRef] [PubMed]
- Chakraborty, K.; Singh, A.L.; Bhaduri, D.; Sairam, R.K. Mechanism of Salinity Stress Tolerance in Crop Plants and Recent Developments. In Advances in Plant Physiology—An International Treatise Series; Hemantaranjan, A., Ed.; Scientific Publishers: Jodhpur, India, 2013; pp. 466–496. [Google Scholar]
- Cira-Chávez, L.A.; Guevara-Luna, J.; YadiraSoto-Padilla, M.; Román-Ponce, B.; Vásquez-Murrieta, M.S.; Estrada-Alvarado, M.I. Kinetics of Halophilic Enzymes. In Kinetics of Enzymatic Synthesis; Rajendran, L., Fernandez, C., Eds.; IntechOpen: London, UK, 2018; pp. 3–26. [Google Scholar] [CrossRef]
- Correa, P.A.; Nosheen, A.; Yasmin, H.; Ali, M.A. Regulatory Role of Microbial Inoculants to Induce Salt Stress Tolerance in Horticulture Crops. In Sustainable Horticulture; Seymen, M., Kurtar, E.S., Erdinc, C., Kumar, A., Eds.; Academic Press: Islamabad, Pakistan, 2022; pp. 125–155. [Google Scholar] [CrossRef]
- Teo, H.M.; Bhubalan, K. Setting a Plausible Route for Saline Soil-Based Crop Cultivations by Application of Beneficial Halophyte-Associated Bacteria. Microorganisms 2022, 10, 657. [Google Scholar] [CrossRef] [PubMed]
- Zhou, N.; Zhao, S.; Tian, C.Y. Effect of Halotolerant Rhizobacteria Isolated from Halophytes on the Growth of Sugar Beet (Beta vulgaris L.) under Salt Stress. FEMS Microbiol. Lett. 2017, 364, fnx091. [Google Scholar] [CrossRef]
- Sharma, S.; Kulkarni, J.; Jha, B. Halotolerant Rhizobacteria Promote Growth and Enhance Salinity Tolerance in Peanut. Front. Microbiol. 2016, 7, 1600. [Google Scholar] [CrossRef]
- Reang, L.; Bhatt, S.; Tomar, R.S. Plant Growth Promoting Characteristics of Halophilic and Halotolerant Bacteria Isolated from Coastal Regions of Saurashtra Gujarat. Sci. Rep. 2022, 12, 4699. [Google Scholar] [CrossRef]
- Spaepen, S.; Vanderleyden, J.; Remans, R. Indole-3-Acetic Acid in Microbial and Microorganism-Plant Signaling. FEMS Microbiol. Rev. 2007, 31, 425–448. [Google Scholar] [CrossRef]
- Nakbanpote, W.; Panitlurtumpai, N.; Sangdee, A.; Sakulpone, N.; Sirisom, P.; Pimthong, A. Salt-Tolerant and Plant Growth-Promoting Bacteria Isolated from Zn/Cd Contaminated Soil: Identification and Effect on Rice under Saline Conditions. J. Plant Interact. 2014, 9, 379–387. [Google Scholar] [CrossRef]
- Kıvanç, M.; Dombaycı, N. Production of Poly-Β-Hydroxybutyric Acid by Rhizobium sp. Fresenius Environ. Bull. 2016, 25, 1305–1311. [Google Scholar]
- Ma, L.; Zhang, Z.; Li, J.; Yang, X.; Fei, B.; Leung, P.H.M.; Tao, X.M. A New Antimicrobial Agent: Poly (3-Hydroxybutyric Acid) Oligomer. Macromol. Biosci. 2019, 19, 1800432. [Google Scholar] [CrossRef]
- Abou-Aiad, T.H.M. Morphology and Dielectric Properties of Polyhydroxybutyrate (PHB)/Poly(Methylmethacrylate)(PMMA) Blends with Some Antimicrobial Applications. Polym. Plast. Technol. Eng. 2007, 46, 435–439. [Google Scholar] [CrossRef]
- Parada-Pinilla, M.P.; Ferreira, M.A.; Roncallo, J.C.; Santos, S.N.; Melo, I.S.; Assef, A.N.B.; Wilke, D.V.; Silva, L.F.; Garrido, L.M.; Araujo, W.L.; et al. Biopolymer Production by Halotolerant Bacteria Isolated from Caatinga Biome. Braz. J. Microbiol. 2021, 52, 547–559. [Google Scholar] [CrossRef] [PubMed]
- Dutta, B.; Bandopadhyay, R. Biotechnological Potentials of Halophilic Microorganisms and Their Impact on Mankind. Beni. Suef. Univ. J. Basic Appl. Sci. 2022, 11, 75. [Google Scholar] [CrossRef] [PubMed]
- Pekmezovic, M.; Kalagasidis Krusic, M.; Malagurski, I.; Milovanovic, J.; Stępień, K.; Guzik, M.; Charifou, R.; Babu, R.; O’Connor, K.; Nikodinovic-Runic, J. Polyhydroxyalkanoate. Antifungal Polyene Formulations with Monomeric Hydroxyalkanoic Acids for Improved Antifungal Efficiency. Antibiotics 2021, 10, 737. [Google Scholar] [CrossRef]
- Food and Agriculture Organization of the United Nations. Available online: https://www.fao.org/resources/digital-reports/disasters-in-agriculture/en/ (accessed on 24 October 2022).
- Egamberdieva, D.; Davranov, K.; Wirth, S.; Hashem, A.; Abd_Allah, E. Impact of Soil Salinity on the Plant-Growth—Promoting and Biological Control Abilities of Root Associated Bacteria. Saudi J. Biol. Sci. 2017, 24, 1601–1608. [Google Scholar] [CrossRef]
- Prittesh, P.; Avnika, P.; Kinjal, P.; Jinal, H.; Sakthivel, K.; Amaresan, N. Amelioration Effect of Salt-Tolerant Plant Growth-Promoting Bacteria on Growth and Physiological Properties of Rice (Oryza sativa) under Salt-Stressed Conditions. Arch. Microbiol. 2020, 202, 2419–2428. [Google Scholar] [CrossRef]
- Kumar, V.; Shriram, V.; Hossain, M. Engineering Proline Metabolism for Enhanced Plant Salt Stress Tolerance. In Managing Salinity Tolerance in Plants: Molecular and Genomic Perspectives; Wani, S., Hussain, M., Eds.; Taylor & Francis: Oxfordshire, UK, 2015; pp. 133–155. [Google Scholar]
- Huang, Z.; Zhao, L.; Chen, D.; Liang, M.; Liu, Z.; Shao, H.; Long, X. Salt Stress Encourages Proline Accumulation by Regulating Proline Biosynthesis and Degradation in Jerusalem Artichoke Plantlets. PLoS ONE 2013, 8, e62085. [Google Scholar] [CrossRef]
- Siddiqui, Z.S.; Wei, X.; Umar, M.; Abideen, Z.; Zulfiqar, F.; Chen, J.; Hanif, A.; Dawar, S.; Dias, D.A.; Yasmeen, R. Scrutinizing the Application of Saline Endophyte to Enhance Salt Tolerance in Rice and Maize Plants. Front. Plant Sci. 2022, 12, 770084. [Google Scholar] [CrossRef]
- Ping, K.S.; Zakaria, R.; Subramaniam, S. Ascorbate Peroxidase Activity of Aranda Broga Blue Orchid Protocorm-Like Bodies (PLBs) In Response to PVS2 Cryopreservation Method. Trop. Life Sci. Res. 2016, 27, 139–143. [Google Scholar] [CrossRef]
- Al-Taweel, K.; Iwaki, T.; Yabuta, Y.; Shigeoka, S.; Murata, N.; Wadano, A. A Bacterial Transgene for Catalase Protects Translation of D1 Protein during Exposure of Salt-Stressed Tobacco Leaves to Strong Light. Plant Physiol. 2007, 145, 258–265. [Google Scholar] [CrossRef]
- Selvakumar, G.; Shagol, C.C.; Kim, K.; Han, S.; Sa, T. Spore Associated Bacteria Regulates Maize Root K+/Na+ Ion Homeostasis to Promote Salinity Tolerance during Arbuscular Mycorrhizal Symbiosis. BMC Plant Biol. 2018, 18, 109. [Google Scholar] [CrossRef] [PubMed]
- Ma, Y.; Dias, M.C.; Freitas, H. Drought and Salinity Stress Responses and Microbe-Induced Tolerance in Plants. Front. Plant Sci. 2020, 11, 591911. [Google Scholar] [CrossRef] [PubMed]
- Kapadia, C.; Sayyed, R.Z.; Enshasy, H.A.E.; Vaidya, H.; Sharma, D.; Patel, N.; Malek, R.A.; Syed, A.; Elgorban, A.M.; Ahmad, K.; et al. Halotolerant Microbial Consortia for Sustainable Mitigation of Salinity Stress, Growth Promotion, and Mineral Uptake in Tomato Plants and Soil Nutrient Enrichment. Sustainability 2021, 13, 8369. [Google Scholar] [CrossRef]
- Alam, S.M. Nutrient Uptake by Plants under Stress Conditions. In Handbook of Plant and Crop Stress; Pessarakli, M., Ed.; Marcel Dekker, Inc.: New York, NY, USA, 1999; pp. 285–313. [Google Scholar]

| Average Size of Inhibition Halos (cm) | |||
|---|---|---|---|
| Fusarium graminearum | Fusarium solani | Fusarium oxysporum | Alternaria alternata |
| 1.6 ± 0.06 | 2.3 ± 0.08 | 3.5 ± 0.1 | - |
| Treatment | Shoot Biomass, g | Root Biomass, g | Shoot Length, cm | Root Length, cm | |
|---|---|---|---|---|---|
| Without NaCl | Control | 5.49 ± 0.17 a | 2.35 ± 0.17 a | 19.7 ± 0.7 a | 15.2 ± 0.5 a |
| Ps. flavescens D5 | 6.21 ± 0.18 b | 3.45 ± 0.14 b | 22.9 ± 0.9 b | 18.1 ± 0.7 b | |
| NaCl 3 g kg−1 | Control | 4.12 ± 0.11 a | 1.87 ± 0.09 a | 16.2 ± 0.7 a | 11.4 ± 1.7 a |
| Ps. flavescens D5 | 4.75 ± 0.14 b | 2.25 ± 0.09 b | 21.5 ± 1.4 b | 17.9 ± 1.1 b | |
| NaCl 4 g kg−1 | Control | 3.54 ± 0.1 a | 1.71 ± 0.04 a | 14.5 ± 1.1 a | 10.1 ± 1.3 a |
| Ps. flavescens D5 | 3.88 ± 0.05 b | 1.92 ± 0.05 b | 20.2 ± 1.5 b | 16.5 ± 1.1 b | |
| NaCl 5 g kg−1 | Control | 3.36 ± 0.1 a | 1.67 ± 0.05 a | 13.2 ± 1.0 a | 9.2 ± 0.9 a |
| Ps. flavescens D5 | 3.9 ± 0.12 b | 1.85 ± 0.04 b | 18.8 ± 1.5 b | 15.6 ± 0.9 b | |
| NaCl 6 g kg−1 | Control | 2.78 ± 0.14 a | 1.53 ± 0.03 a | 12.5 ± 1.1 a | 8.7 ± 0.7 a |
| Ps. flavescens D5 | 3.62 ± 0.18 b | 1.64 ± 0.02 b | 16.5 ± 0.9 b | 14.1 ± 1.3 b | |
| Treatment | Chlorophyll a, mg g−1 | Chlorophyll b, mg g−1 | |
|---|---|---|---|
| Without NaCl | Control | 2.19 ± 0.02 a | 1.18 ± 0.02 a |
| Ps. flavescens D5 | 2.37 ± 0.01 b | 1.56 ± 0.02 b | |
| NaCl 3 g kg−1 | Control | 1.44 ± 0.03 a | 0.80 ± 0.02 a |
| Ps. flavescens D5 | 1.71 ± 0.01 b | 0.92 ± 0.03 b | |
| NaCl 4 g kg−1 | Control | 1.02 ± 0.01 a | 0.76 ± 0.03 a |
| Ps. flavescens D5 | 1.55 ± 0.02 b | 0.86 ± 0.01 b | |
| NaCl 5 g kg−1 | Control | 0.90 ± 0.02 a | 0.67 ± 0.01 a |
| Ps. flavescens D5 | 1.35 ± 0.03 b | 0.72 ± 0.03 b | |
| NaCl 6 g kg−1 | Control | 0.79 ± 0.04 a | 0.62 ± 0.02 a |
| Ps. flavescens D5 | 1.15 ± 0.02 b | 0.69 ± 0.01 b | |
| Treatment | Catalase, μmol min−1 mg of Protein−1 | Ascorbate Peroxidase, μmol min−1 mg of Protein−1 | Guaiacol Peroxidase, μmol min−1 mg of Protein−1 | |
|---|---|---|---|---|
| Without NaCl | Control | 0.046 ± 0.001 a | 7.2 ± 0.3 a | 12.3 ± 0.5 a |
| Ps. flavescens D5 | 0.049 ± 0.001 a | 7.4 ± 0.2 a | 12.6 ± 0.4 a | |
| NaCl 3 g kg−1 | Control | 0.087 ± 0.002 a | 4.6 ± 0.2 a | 13.13 ± 0.6 a |
| Ps. flavescens D5 | 0.12 ± 0.003 b | 9.2 ± 0.4 b | 27.1 ± 0.7 b | |
| NaCl 4 g kg−1 | Control | 0.065 ± 0.001 a | 5.75 ± 0.2 a | 16.26 ± 0.6 a |
| Ps. flavescens D5 | 0.23 ± 0.01 b | 16.05 ± 0.7 b | 34.1 ± 1.7 b | |
| NaCl 5 g kg−1 | Control | 0.063 ± 0.003 a | 6.3 ± 0.2 a | 23.1 ± 0.8 a |
| Ps. flavescens D5 | 0.38 ± 0.005 b | 12.7 ± 0.5 b | 29.2 ± 1.1 b | |
| NaCl 6 g kg−1 | Control | 0.058 ± 0.002 a | 8.04 ± 0.3 a | 20.3 ± 0.7 a |
| Ps. flavescens D5 | 0.37 ± 0.01 b | 10.75 ± 0.4 b | 25.3 ± 1.1 b | |
| Treatment | Content of Elements, ×103 mg kg−1 | ||||||
|---|---|---|---|---|---|---|---|
| Na+ | K+ | Mg2+ | Ca2+ | Mn2+ | Fe3+ | ||
| Without NaCl | Control | 2.9 ± 0.03 a | 30.4 ± 1.9 a | 1.8 ± 0.27 a | 7.2 ± 0.71 a | 4.1 ± 0.62 a | 0.13 ± 0.02 a |
| Ps. flavescens D5 | 3.0 ± 0.04 a | 33.8 ± 1.6 a | 2.0 ± 0.03 a | 8.2 ± 0.12 a | 4.6 ± 0.69 a | 0.19 ± 0.03 a | |
| NaCl 3 g kg−1 | Control | 3.8 ± 0.06 b | 23.6 ± 1.8 a | 2.2 ± 0.01 b | 4.5 ± 0.07 a | 5.24 ± 0.76 a | 0.12 ± 0.03 a |
| Ps. flavescens D5 | 1.6 ± 0.02 a | 24.4 ± 1.6 a | 1.7 ± 0.02 a | 6.3 ± 0.09 b | 5.60 ± 0.98 a | 0.16 ± 0.02 a | |
| NaCl 4 g kg−1 | Control | 5.4 ± 0.08 b | 27.3 ± 1.0 a | 3.7 ± 0.05 b | 3.99 ± 0.05 a | 5.4 ± 0.82 a | 0.16 ± 0.02 a |
| Ps. flavescens D5 | 2.96 ± 0.03 a | 29.8 ± 1.2 a | 2.6 ± 0.07 a | 4.3 ± 0.03 b | 4.96 ± 0.29 a | 0.13 ± 0.02 a | |
| NaCl 5 g kg−1 | Control | 7.6 ± 0.01 b | 26.6 ± 1.7 a | 3.9 ± 0.08 b | 3.7 ± 0.05 a | 6.6 ± 0.10 a | 0.13 ± 0.02 a |
| Ps. flavescens D5 | 5.8 ± 0.08 a | 28.5 ± 1.4 a | 2.1 ± 0.06 a | 4.3 ± 0.04 b | 5.8 ± 0.87 a | 0.15 ± 0.02 a | |
| NaCl 6 g kg−1 | Control | 7.8 ± 0.01 b | 29.3 ± 1.3 a | 3.7 ± 0.54 b | 3.9 ± 0.05 a | 4.6 ± 0.10 a | 0.17 ± 0.02 a |
| Ps. flavescens D5 | 7.6 ± 0.01 a | 34.9 ± 1.4 b | 1.7 ± 0.02 a | 6.3 ± 0.53 b | 5.8 ± 0.12 a | 0.15 ± 0.02 a | |
Publisher’s Note: MDPI stays neutral with regard to jurisdictional claims in published maps and institutional affiliations. |
© 2022 by the authors. Licensee MDPI, Basel, Switzerland. This article is an open access article distributed under the terms and conditions of the Creative Commons Attribution (CC BY) license (https://creativecommons.org/licenses/by/4.0/).
Share and Cite
Ignatova, L.; Usmanova, A.; Brazhnikova, Y.; Omirbekova, A.; Egamberdieva, D.; Mukasheva, T.; Kistaubayeva, A.; Savitskaya, I.; Karpenyuk, T.; Goncharova, A. Plant Probiotic Endophytic Pseudomonas flavescens D5 Strain for Protection of Barley Plants from Salt Stress. Sustainability 2022, 14, 15881. https://doi.org/10.3390/su142315881
Ignatova L, Usmanova A, Brazhnikova Y, Omirbekova A, Egamberdieva D, Mukasheva T, Kistaubayeva A, Savitskaya I, Karpenyuk T, Goncharova A. Plant Probiotic Endophytic Pseudomonas flavescens D5 Strain for Protection of Barley Plants from Salt Stress. Sustainability. 2022; 14(23):15881. https://doi.org/10.3390/su142315881
Chicago/Turabian StyleIgnatova, Lyudmila, Aizhamal Usmanova, Yelena Brazhnikova, Anel Omirbekova, Dilfuza Egamberdieva, Togzhan Mukasheva, Aida Kistaubayeva, Irina Savitskaya, Tatyana Karpenyuk, and Alla Goncharova. 2022. "Plant Probiotic Endophytic Pseudomonas flavescens D5 Strain for Protection of Barley Plants from Salt Stress" Sustainability 14, no. 23: 15881. https://doi.org/10.3390/su142315881
APA StyleIgnatova, L., Usmanova, A., Brazhnikova, Y., Omirbekova, A., Egamberdieva, D., Mukasheva, T., Kistaubayeva, A., Savitskaya, I., Karpenyuk, T., & Goncharova, A. (2022). Plant Probiotic Endophytic Pseudomonas flavescens D5 Strain for Protection of Barley Plants from Salt Stress. Sustainability, 14(23), 15881. https://doi.org/10.3390/su142315881








